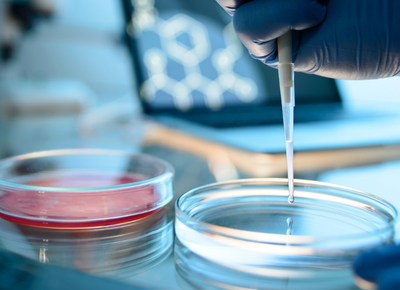

Nutrition & Santé
Étudier et valoriser l’impact santé de vos produits
Nos expertises
Face aux attentes croissantes des consommateurs en matière de nutrition et de santé, les entreprises doivent démontrer scientifiquement les bénéfices de leurs produits.
L’équipe Nutrition & Santé d’ITERG vous accompagne pour évaluer, comprendre et valoriser l’impact nutritionnel de vos ingrédients et formulations.
Biodisponibilité des nutriments
Étudier le devenir métabolique des lipides et composés bioactifs.
Évaluation nutritionnelle
Mesurer la valeur nutritionnelle et la digestibilité de vos produits.
Bioessais & modèles expérimentaux
Études in vitro et in vivo pour comprendre les mécanismes biologiques.
Support scientifique
Produire des données et des arguments scientifiques pour vos innovations.

Vos problématiques industrielles
Les acteurs de l’agroalimentaire et du nutraceutique doivent aujourd’hui :
-
démontrer les bénéfices santé de leurs ingrédients ou formulations
-
comprendre la biodisponibilité des nutriments
-
évaluer l’impact nutritionnel de nouveaux produits
-
disposer de preuves scientifiques crédibles
Entre innovation produit, réglementation et attentes consommateurs, l’appui scientifique devient essentiel.
Nos solutions

BIOESSAIS
Évaluer l’impact biologique
de vos ingrédients
Nous concevons des bioessais pour étudier la digestibilité et la biodisponibilité des composés nutritionnels.
- Études in vitro et in vivo
- Évaluation de la biodisponibilité
- Digestibilité des lipides et protéines
- Identification de biomarqueurs

ANALYSES BIOLOGIQUES
Caractériser les nutriments
dans les matrices biologiques
Nos laboratoires analysent les composés bioactifs dans différents échantillons biologiques.
- Dosage des acides gras et lipides
- Analyses plasma, tissus, lait maternel
- Caractérisation de biomarqueurs
- Analyses à haut débit
SUPPORT SCIENTIFIQUE
Valoriser vos résultats
et renforcer votre crédibilité
Nous accompagnons vos équipes dans l’exploitation scientifique des données.
- Conception d’études nutritionnelles
- Interprétation des résultats
- Rédaction scientifique
- Appui aux projets d’innovation
Parlons de votre projet
Nos experts sont à votre écoute pour analyser vos besoins et vous proposer des solutions sur-mesure.
Contactez-nous pour échanger en toute confidentialité sur votre projet.

